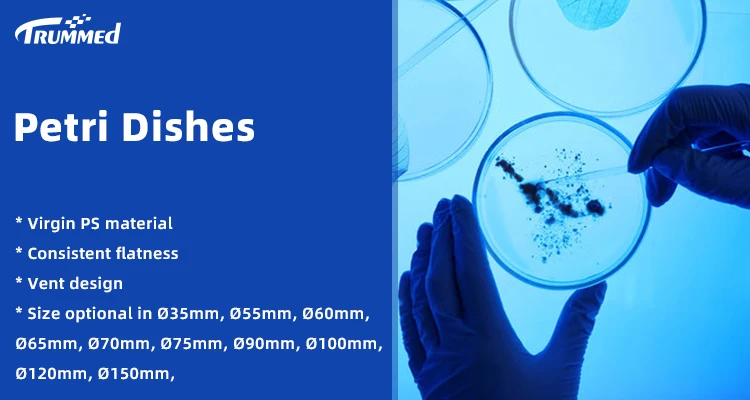

Лабораторные Расходные чаши Петри Прозрачная Круглая Чаша из полистирола на заказ 60 мм
- Категории: Lab Supplies >>>
- Поставщик: Trummed,Medical,(hangzhou),Co.,Ltd.
Поделиться:
Описание и отзывы
Характеристики
Product Description
Petri dishes is a laboratory utensil used for the culture of microorganisms or cells. It can be used for laboratory inoculation, streaking, bacterial isolation operations and plant germination.
* Made of virgin PS material
* Transparent PS material easy to observe, more convenient for experiment
* Vent design for easy air exchange
* Easy to stack up with the stack up circle.
* The dish bottom is smooth and clean without deformation
* E.O or Gamma radiation sterile available
* Made of virgin PS material
* Transparent PS material easy to observe, more convenient for experiment
* Vent design for easy air exchange
* Easy to stack up with the stack up circle.
* The dish bottom is smooth and clean without deformation
* E.O or Gamma radiation sterile available

Code & Packing
Peri Dish | ||||||||||||||||
Product Code | Size(mm) | Material | Shape | Room | Vent | Sterile | Packaging | CTN Meas.(cm) | ||||||||
161-0351 | Φ35x15 | PS | Round | 1 | 3 | E.O. | 10pcs/bag, 2000pcs/ctn | 42x42x27 | ||||||||
161-0601 | Φ60x15 | PS | Round | 1 | 3 | E.O. | 56x42x30 | |||||||||
161-0651 | Φ65x15 | PS | Round | Grid | 4 | E.O. | 63x31x32 | |||||||||
161-0901 | Φ90x15 (12.6g) | PS | Round | 1 | 3 | E.O. | 46x46x31 | |||||||||
161-0902 | Φ90x15 (14g) | PS | Round | 1 | 3 | E.O. | 46x46x31 | |||||||||
161-0903 | Φ90x15 | PS | Round | 1 | No | E.O. | 46x46x31 | |||||||||
161-0904 | Φ90x15 | PS | Round | 2 | 3 | E.O. | 46x46x31 | |||||||||
161-0905 | Φ90x15 | PS | Round | 3 | 3 | E.O. | 46x46x31 | |||||||||
161-0906 | Φ90x15 | PS | Round | 4 | 3 | E.O. | 46x46x31 | |||||||||
161-1001 | Φ100x15 | PS | Round | 1 | 3 | E.O. | 10pcs/bag, 240pcs/ctn | 50x50x31 | ||||||||
161-1501 | Φ150x15 | PS | Round | 1 | 3 | E.O. | 61x46x46 | |||||||||
161-1002 | 100x100x15 | PS | Square | Grid | 4 | E.O. | 50x30x36 | |||||||||
161-1003 | 100x100x15 | PS | Square | 1 | 4 | E.O. | 50x30x36 | |||||||||
161-1301 | 130x130x15 | PS | Square | Grid | 4 | E.O. | 65x40x35 | |||||||||
161-1302 | 130x130x15 | PS | Square | 1 | 4 | E.O. | 65x40x35 | |||||||||
Hot sale products

FAQ
Q1:Why choose us?
(1) 10+ Years experience in laboratory consumables
(2) Class 100,000 cleaning room Production Environment
(3) Strict QC system according to ISO13485
(4) All finished product can be traced, excellent After- Sales guarantee
(5) Timely delivery guaranteed
(2) Class 100,000 cleaning room Production Environment
(3) Strict QC system according to ISO13485
(4) All finished product can be traced, excellent After- Sales guarantee
(5) Timely delivery guaranteed
Q2: Can I visit your factory?
Sure, warmly welcome your visit to our factory. Please try to contact our sales representative first, we will make the appointment and the most reasonable planning for your transportation.
Sure, warmly welcome your visit to our factory. Please try to contact our sales representative first, we will make the appointment and the most reasonable planning for your transportation.
Q3: What is your minimum order quantity?
The MOQ for petri dishes is 1 carton. For customization service, depend on your requirements.
The MOQ for petri dishes is 1 carton. For customization service, depend on your requirements.
Q4: Can you supply free samples?
Yes, we would like to offer you free samples within 3 days.
Yes, we would like to offer you free samples within 3 days.
Q5: Can you offer customized service?
Yes, both OEM and ODM are available. Let me know your idea or requirements on the products, we make it perfect for you.
Yes, both OEM and ODM are available. Let me know your idea or requirements on the products, we make it perfect for you.
Q6: How long is your delivery time?
Generally 10-25 days for mass production after sample confirmed and the receipt of formal PO or deposit.
Generally 10-25 days for mass production after sample confirmed and the receipt of formal PO or deposit.
Q7:What is your accepted terms of payment?
Various choice: T/T, Western union, Paypal, Alipay, L/C, etc. 30% down payment or 100% full payment according to your order quantity.
Various choice: T/T, Western union, Paypal, Alipay, L/C, etc. 30% down payment or 100% full payment according to your order quantity.
Похожие товары
504201, 96 лунцевых пластин ELISA с высокой связью
US $1.00-$1.50
Портативный термофлюорометр
US $4200-$4600






































